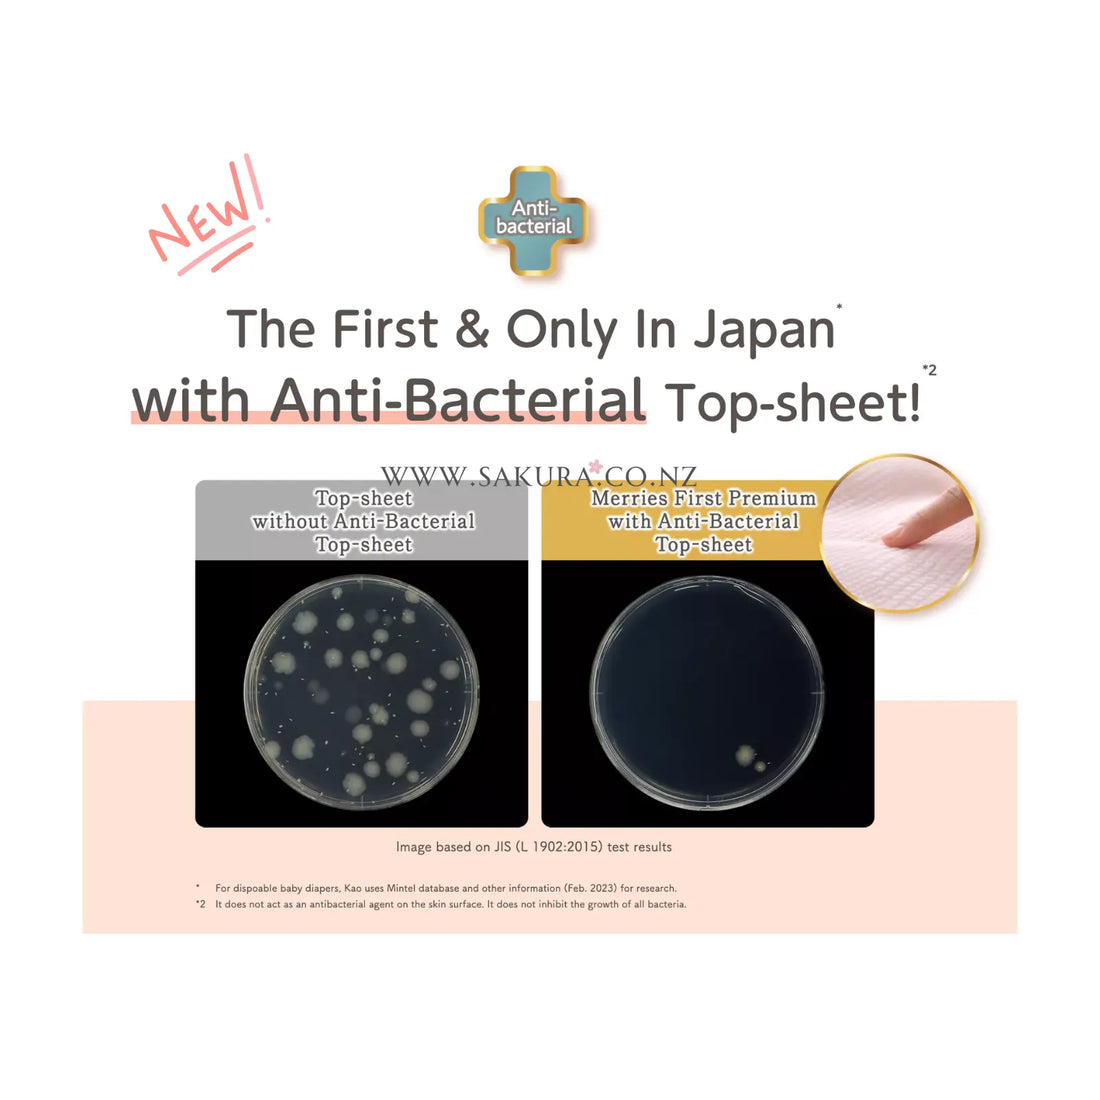

51 产品
-

 Merries 花王顶级纸尿裤 日本制造 五星纸(尿片) NB(5 公斤以下)66 片品牌Merries 花王顶级纸尿裤 日本制造 五星纸(尿片) NB(5 公斤以下)66 片Merries
Merries 花王顶级纸尿裤 日本制造 五星纸(尿片) NB(5 公斤以下)66 片品牌Merries 花王顶级纸尿裤 日本制造 五星纸(尿片) NB(5 公斤以下)66 片Merries- 正常价格
-
$18.90 NZD - 正常价格
-
$29.90 NZD - 特卖价格
-
$18.90 NZD
💥 BIG SAVE! 💥快速查看
-

 Merries First Premium 日本花王顶级白金尿片 (贴纸)S(4-8 公斤)60片品牌Merries First Premium 日本花王顶级白金尿片 (贴纸)S(4-8 公斤)60片Merries
Merries First Premium 日本花王顶级白金尿片 (贴纸)S(4-8 公斤)60片品牌Merries First Premium 日本花王顶级白金尿片 (贴纸)S(4-8 公斤)60片Merries- 正常价格
-
$22.90 NZD - 正常价格
-
$33.90 NZD - 特卖价格
-
$22.90 NZD
快速查看
-

 Merries First Premium 花王顶级白金拉拉裤 M (6-11 公斤) 46 片品牌Merries First Premium 花王顶级白金拉拉裤 M (6-11 公斤) 46 片Merries
Merries First Premium 花王顶级白金拉拉裤 M (6-11 公斤) 46 片品牌Merries First Premium 花王顶级白金拉拉裤 M (6-11 公斤) 46 片Merries- 正常价格
-
$22.90 NZD - 正常价格
-
$33.90 NZD - 特卖价格
-
$22.90 NZD
快速查看
-

 Moony 尤妮佳 日本版 低刺激温柔呵护 贴式纸尿裤(Tape) 新生儿码(5kg以下)60片装品牌Moony 尤妮佳 日本版 低刺激温柔呵护 贴式纸尿裤(Tape) 新生儿码(5kg以下)60片装Moony
Moony 尤妮佳 日本版 低刺激温柔呵护 贴式纸尿裤(Tape) 新生儿码(5kg以下)60片装品牌Moony 尤妮佳 日本版 低刺激温柔呵护 贴式纸尿裤(Tape) 新生儿码(5kg以下)60片装Moony- 正常价格
-
$23.90 NZD - 正常价格
-
$29.90 NZD - 特卖价格
-
$23.90 NZD
快速查看
-

 Moony Nappies 尤妮佳日版(贴片) 纸尿裤 XL (12-17kg) 44片品牌Moony Nappies 尤妮佳日版(贴片) 纸尿裤 XL (12-17kg) 44片Moony
Moony Nappies 尤妮佳日版(贴片) 纸尿裤 XL (12-17kg) 44片品牌Moony Nappies 尤妮佳日版(贴片) 纸尿裤 XL (12-17kg) 44片Moony- 正常价格
-
$22.99 NZD - 正常价格
-
$29.90 NZD - 特卖价格
-
$22.99 NZD
快速查看